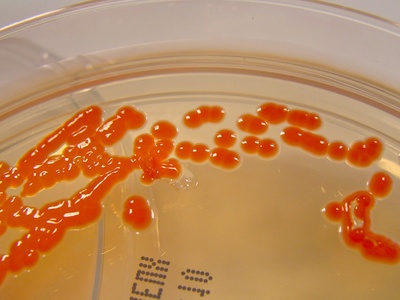
Pigmented colony

In field sites and bench-top labs alike, microbes display a huge range of lifestyles that shape ecosystems and experimental outcomes. Noticing those differences — from organisms that thrive in extreme pH to cultures that simply go cloudy — helps you interpret samples and design experiments.
There are 36 Types of Microbial Growth, ranging from Acidophile to Turbid culture. For each entry you’ll find below the Defining condition, Typical organisms, Lab appearance so you can quickly compare environmental drivers, representative taxa, and what to expect on plates or in broth — you’ll find all of that below.
How do environmental conditions determine different types of microbial growth?
Environmental factors like pH, temperature, oxygen availability, salinity and nutrient sources select for different growth types: acidophiles prefer low pH, thermophiles high temperatures, aerobes need oxygen while anaerobes cannot tolerate it. Changing any of these parameters in the lab will favor organisms adapted to those conditions, so matching growth conditions to suspected physiology is the fastest way to enrich for a particular type.
How can I recognize different growth types in the lab without sequencing?
Start with macroscopic clues: colony shape and color on plates, turbidity or flocculation in broth, and growth patterns in oxygen gradients (e.g., thioglycollate tubes). Combine those observations with selective media, temperature or pH shifts and a few simple biochemical or microscopy checks to narrow the likely growth category.
Types of Microbial Growth
| Name | Defining condition | Typical organisms | Lab appearance |
|---|---|---|---|
| Lag phase | Adaptation period before cell division | Most bacteria (Escherichia coli,Bacillus subtilis) | No increase in turbidity; few small colonies |
| Log (Exponential) phase | Constant maximum growth rate under ideal conditions | Escherichia coli,Bacillus subtilis | Rapid increase in turbidity; many uniform colonies |
| Stationary phase | Nutrient limitation or waste accumulation halts net growth | Most bacteria (various species) | Stable turbidity; smaller colony yields |
| Death (Decline) phase | Net loss of viable cells due to stress or starvation | Most bacteria under prolonged culture | Decreasing turbidity; fewer viable colonies |
| Obligate aerobe | Requires oxygen for growth | Pseudomonas aeruginosa,Mycobacterium tuberculosis | Growth only near air interface on broth or agar |
| Facultative anaerobe | Grows with or without oxygen; prefers oxygen | Escherichia coli,Staphylococcus aureus | Growth throughout broth; denser near surface |
| Obligate anaerobe | Cannot tolerate oxygen; inhibited or killed by it | Clostridium sporogenes,Bacteroides fragilis | Growth only in oxygen-free zones; sediment or anaerobic plates |
| Microaerophile | Requires low oxygen levels (reduced O2) | Campylobacter jejuni,Helicobacter pylori | Growth in reduced-O2 zone on agar or candle jar |
| Aerotolerant anaerobe | Unaffected by oxygen; ferments regardless of O2 | Lactobacillus spp.,Streptococcus spp. | Uniform growth throughout broth; no surface preference |
| Photoautotroph | Uses light as energy and CO2 as carbon source | Synechococcus spp.,Prochlorococcus spp. | Green or pigmented mats; surface mats in illuminated cultures |
| Chemoautotroph (Chemolithotroph) | Oxidizes inorganic compounds as energy source | Nitrosomonas europaea,Thiobacillus spp. | Growth in mineral media; biofilms on minerals |
| Chemoheterotroph (Chemoorganotroph) | Uses organic compounds for energy and carbon | Escherichia coli,Bacillus subtilis | Turbid broths; diverse colony morphologies |
| Psychrophile | Optimum growth at cold temperatures (<15°C) | Psychrobacter spp.,Colwellia psychrerythraea | Growth on cold-incubated plates; slow colony development |
| Psychrotroph | Tolerates cold; grows at refrigeration temperatures | Listeria monocytogenes,Pseudomonas fluorescens | Slow growth at 4–10°C; colonies appear after days |
| Mesophile | Optimum growth at moderate temperatures (~20–45°C) | Escherichia coli,Bacillus subtilis | Rapid growth at room/body temperature; clear turbidity |
| Thermophile | Optimum growth at elevated temperatures (45–80°C) | Geobacillus stearothermophilus,Bacillus thermophilus | Growth on heated cultures; heat-stable colonies |
| Hyperthermophile | Optimum growth above ~80°C | Pyrococcus furiosus,Thermococcus spp. | Growth in extreme-heat bioreactors; specialized media |
| Acidophile | Optimum growth at low pH (acidic) | Acidithiobacillus ferrooxidans,Ferrovum spp. | Growth on acidic media; biofilms on minerals |
| Neutrophile | Optimum growth near neutral pH (~6.5–7.5) | Escherichia coli,Bacillus subtilis | Normal growth on standard media; typical colonies |
| Alkaliphile | Optimum growth at high pH (alkaline) | Bacillus alcalophilus,Natronomonas spp. | Growth on alkaline media; colonies often slow-growing |
| Halophile | Requires elevated salt concentrations for growth | Halobacterium salinarum,Dunaliella salina | Growth in hypersaline media; red/orange pigmented films |
| Halotolerant | Tolerates high salt but doesn’t require it | Staphylococcus aureus,Debaryomyces hansenii | Grows on both low- and high-salt media; colonies present |
| Turbid culture | Uniform cloudiness throughout liquid medium | Many bacteria (E.coli,Bacillus spp.) | Even opacity in broth from dispersed cells |
| Pellicle | Surface-floating film on standing liquid | Pseudomonas spp.,Acetobacter spp. | Thin to thick surface film; often wrinkled |
| Sediment (Bottom growth) | Cells settle or grow at tube bottom | Anaerobes,some facultatives (Clostridium spp.) | Dense pellet or layer at broth bottom |
| Flocculent growth | Visible loose aggregates in liquid culture | Yeasts (Saccharomyces),bacteria (Clostridium) | Suspended clumps or flakes in broth; cloudy patches |
| Biofilm | Surface-attached community in extracellular matrix | Pseudomonas aeruginosa,Staphylococcus epidermidis | Sticky, structured surface films; microcolonies visible |
| Confluent lawn | Dense, continuous growth covering agar | Many bacteria in plate assays (E.coli) | Opaque, even growth across agar surface |
| Circular colony | Round, symmetrical colony shape | Escherichia coli,Micrococcus luteus | Round, smooth-edged colonies on agar |
| Irregular colony | Uneven, non-circular colony outline | Pseudomonas aeruginosa,Bacillus cereus | Lobed or scalloped margins; variable textures |
| Filamentous colony | Thread-like, branching colony growth | Actinomyces,Nocardia species | Fuzzy, thread-like projections; aerial hyphae may appear |
| Rhizoid colony | Root-like, branching radiating growth | Streptomyces spp.,Bacillus subtilis (variants) | Radial, rootlike spreading from center |
| Punctiform colony | Very small, pinpoint colonies | Many bacteria at low inoculum | Tiny, pinpoint colonies across agar surface |
| Mucoid colony | Slimy, glossy colonies due to capsule | Klebsiella pneumoniae,Pseudomonas aeruginosa (mucoid) | Glistening, sticky colonies; raised surface |
| Pigmented colony | Distinct colony coloration from pigments | Serratia marcescens (red),Pseudomonas aeruginosa (green) | Colored colonies (red,green,yellow) on agar |
| Swarming growth | Rapid surface spread of motile cells | Proteus mirabilis,Serratia spp. | Concentric rings or spreading film across agar |
Images and Descriptions

Lag phase
Initial period after inoculation when cells adjust to new medium, repair damage, and synthesize enzymes. Growth rate is low while metabolism resets; length depends on inoculum size, history, and conditions. Not a dormant state but preparation for active division.

Log (Exponential) phase
Phase of balanced, exponential cell division where population doubles at a characteristic rate. Metabolism is active, making it ideal for growth-rate studies and antibiotic susceptibility tests because most cells are physiologically similar.

Stationary phase
When nutrient depletion or toxic byproducts balance cell division and death. Growth slows, secondary metabolites often appear, stress responses activate, and some cells enter dormancy or form spores. Population size plateaus and physiology changes markedly.

Death (Decline) phase
Population declines as cells die from starvation, autolysis, or toxins. Rate varies with organism and environment; some cells form resistant persisters or spores, while others lyse and release nutrients back into the medium.

Obligate aerobe
Organisms that depend on aerobic respiration; oxygen is the terminal electron acceptor. In liquid culture they grow at the surface where oxygen is available and typically fail to grow anaerobically.

Facultative anaerobe
Flexible metabolism: use oxygen when present for efficient respiration, switch to fermentation or anaerobic respiration otherwise. Common in gut and soils and readily cultured in many lab conditions.

Obligate anaerobe
Lack protective enzymes against reactive oxygen species; require strict anaerobic conditions for culture. Found in deep sediments, gut, and wounds; cultivation needs oxygen-free techniques.

Microaerophile
Grow best at oxygen levels lower than atmospheric; many colonize mucosal surfaces. In lab, microaerophilic jars or specialized incubators supply 2–10% O2 for optimal growth.

Aerotolerant anaerobe
Organisms that tolerate oxygen but do not use it metabolically. They perform fermentation whether oxygen is present or not and survive in mixed oxygen environments.

Photoautotroph
Convert light into chemical energy and fix CO2; common in cyanobacteria and algae. Form surface blooms, mats, or pigmented biofilms in illuminated aquatic and terrestrial habitats.

Chemoautotroph (Chemolithotroph)
Derive energy from inorganic electron donors (e.g., ammonium, sulfide) and fix CO2. Important in biogeochemical cycles and bioremediation; often slow-growing and form niche-specific communities.

Chemoheterotroph (Chemoorganotroph)
Most bacteria and fungi fall here, consuming organic substrates for growth. They display varied colony forms, quick growth in rich media, and are central to decomposition and laboratory cultures.

Psychrophile
Adapted to permanently cold environments like polar oceans and glaciers. Enzymes and membranes remain functional at low temperatures; growth is slow at moderate temperatures and often inhibited above 20°C.

Psychrotroph
Cold-tolerant organisms that grow slowly near 0–7°C but have higher optima. Important in food spoilage and safety because they multiply in refrigerated foods over time.

Mesophile
The majority of lab-friendly bacteria with optima near human body or ambient temperatures. Most clinical, environmental, and industrial microbes are mesophiles; easy to culture under standard incubator settings.

Thermophile
Adapted to hot environments like compost and hot springs. Enzymes are heat-stable and useful in industry; many thermophiles form sturdy spores or heat-resistant cell structures.

Hyperthermophile
Archaea and bacteria adapted to near-boiling conditions in hydrothermal vents. Membranes, proteins, and DNA-stabilizing mechanisms allow growth where few organisms survive.

Acidophile
Prefer or require acidic environments; often involved in metal oxidation and acid mine drainage. Maintain internal pH homeostasis with adapted membranes and proton pumps.

Neutrophile
Most bacteria and fungi are neutrophiles, thriving in neutral pH environments like soils, freshwater, and host tissues. Lab media are usually formulated to this pH range.

Alkaliphile
Adapted to soda lakes, alkaline soils, and industrial settings. Employ systems to export hydroxide ions or import protons to maintain cytoplasmic pH and enzyme function.

Halophile
Organisms, often archaea, dependent on high salinity. Found in salt lakes and saline ponds; unique osmoprotection strategies and vivid pigments are common.

Halotolerant
Can survive and grow across a range of salinities; important in food preservation and human-associated environments. They adapt osmotically without strict dependence on salt.

Turbid culture
Common liquid-culture appearance when cells are planktonic and evenly suspended. Turbidity correlates with cell density and is commonly measured by optical density to estimate growth.

Pellicle
Aerial or surface biofilm formed at the air-liquid interface, often by aerobes or organisms that trap oxygen. Pellicles can indicate surface respiration, cellulose production, or community structure.

Sediment (Bottom growth)
Growth that concentrates at the bottom of standing cultures due to gravity or preference for low-oxygen zones. Common with nonmotile cells, aggregated flocs, or anaerobic populations.

Flocculent growth
Cells form clumps or flocs that settle slowly; typical in wastewater microbes and some fermentations. Flocculation affects sedimentation, clarity, and downstream processing.

Biofilm
Multicellular aggregates attached to surfaces and embedded in polysaccharide matrix. Biofilms are heterogenous, resist removal and antibiotics, and are common on medical devices, pipes, and natural surfaces.

Confluent lawn
Occurs when inoculum density or spreading produces continuous coverage rather than discrete colonies. Used for antibiotic susceptibility tests and streptomycin overlays; hides individual colony morphology.

Circular colony
Common colony form with even radial growth from a single cell. Shape reflects uniform expansion across the agar surface and simple growth without filamentation or branching.

Irregular colony
Results from heterogeneous growth rates at the colony edge, swarming, or complex extracellular structures. Irregular margins help microbiologists distinguish species or growth behaviors.

Filamentous colony
Colonies that form branching filaments resembling fungi; common among actinomycetes and filamentous bacteria. Indicative of hyphal growth, sporulation structures, or filamentous cell morphology.

Rhizoid colony
Characterized by branched, rootlike projections radiating from a central colony. Suggests motile spreading or filamentous growth and is useful diagnostically.

Punctiform colony
Describes very small colonies from minimal growth or slow-growing cells. Punctiform appearance indicates low initial cell numbers or stringent growth requirements.

Mucoid colony
Produced by organisms that secrete extracellular polysaccharide (capsule). Mucoid texture affects colony handling, indicates virulence or biofilm potential, and is visually distinctive.
Pigmented colony
Pigments can be diagnostic, protect against stress, or participate in metabolism. Color intensity often depends on medium, temperature, and light exposure.

Swarming growth
Collective, coordinated movement across moist agar producing spreading patterns or concentric rings. Swarming requires flagella expression and surfactant production; it alters colony morphology dramatically.






